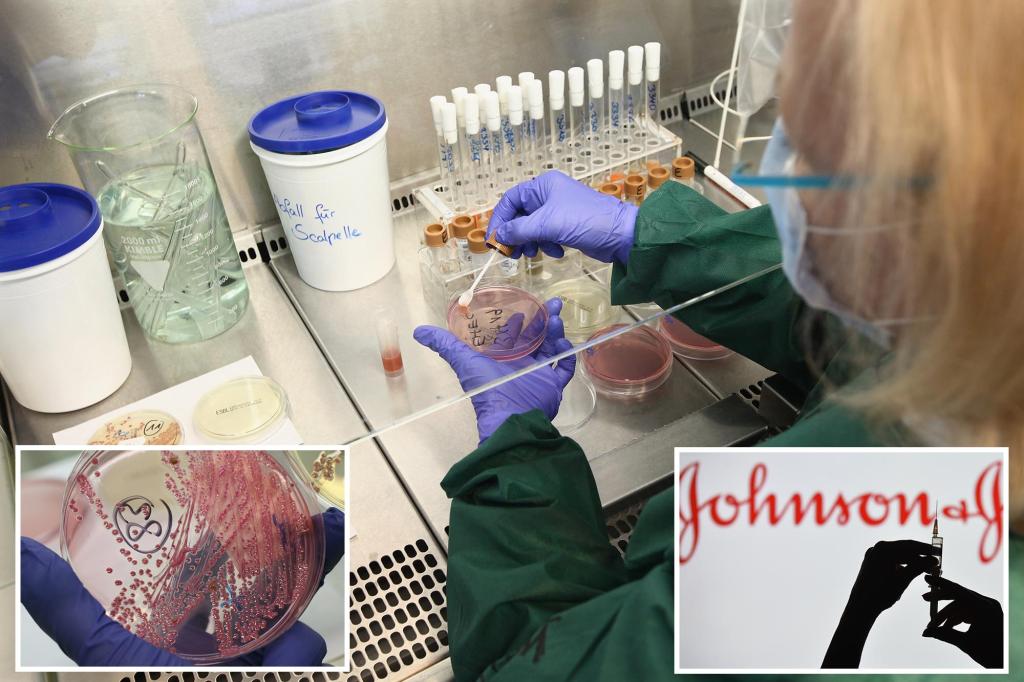

Johnson & Johnson halts late-stage E.coli vaccine trial after poor results
Drug giants Johnson & Johnson and Sanofi have suspended late-stage clinical trials of the experimental E.COLI vaccine after the results failed to demonstrate sufficient efficacy. company It was announced on Thursday The vaccine showed no safety concerns, but did not meet the efficacy threshold required to continue development. The experimental vaccine, known as Expec9V, was […]
Palace coup in a late-stage empire

As a global power and leader of the free world, it is crucial for the United States to know who actually runs its government. The Constitution clearly outlines the distribution of powers. However, conservative voters who have watched the media and the Deep State work together to bring down President Donald Trump are slowly realizing […]